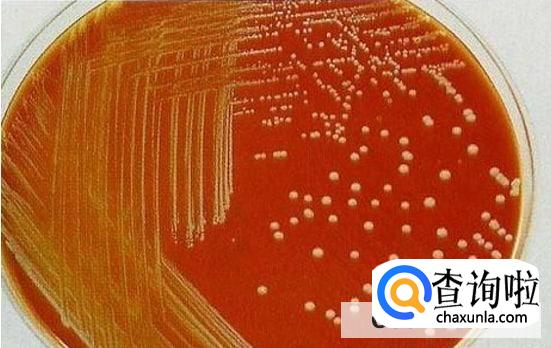
速冻食品何来病菌

最佳回答
本文由作者推荐
简要回答
速冻食品之所以有病菌,主要是因为生产人员本身带有病菌,从而导致速冻食品,在还没有速冻之前,已经造成食物污染,或者说速冻食品在加工的过程中受到了污染,当然速冻食品如果包装不严密,在运输和销售的过程中也容易出现病菌。
详细内容
- 01
通常情况下,速冻食品所产生的病菌为金黄色葡萄球菌,这种病菌是比较常见的,主要分布在土壤,空气人和动物等等身上。

- 02
由于金黄色的葡萄球菌在普通的环境下就能够进行生长并且长势比较好,由于它具有耐盐性,在肉汤中也可以生长,并且会分解成对人体有害的物质。
- 03
虽说速冻食品价格比较便宜,但是建议大家在挑选速冻食品时,一定要挑选生产日期最近的产品,如果说是自家自制的肉类食物,需要将其煮熟蒸透。

- 04
如果说我们一次性购买了大量的肉类食物,此时根本就吃不掉,那么想要合理的保存,需要放到冰箱当中冷冻。这样可以有效的延长食物的保质期,但是需要注意使用这类食物的时候,需要彻底加热。
广告位
点击排行
- 2 排行
- 3 排行
- 4 排行
- 5 排行
- 6 排行
- 7 排行
- 8 排行
- 9 排行
- 10 排行
热点追踪
广告位

